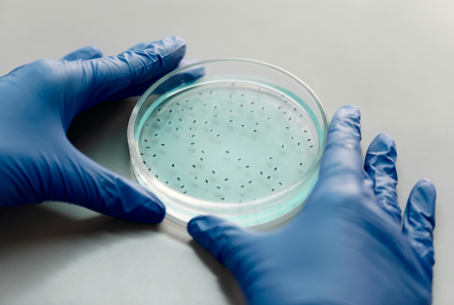

Contaminação da água pelo vizinho: como a análise identifica a origem do problema
A torneira começou a apresentar um odor diferente. Ou a água ficou turva depois que a obra no imóvel ao lado foi concluída. Ou, ainda, um resultado de análise apontou coliformes fecais sem que nenhuma alteração tenha ocorrido dentro da própria edificação.
Em situações como essas, a suspeita recai sobre uma fonte externa: o vizinho, a atividade do terreno ao lado, um vazamento de esgoto próximo. A questão é legítima, e a resposta não vem da observação, vem da análise.
Este guia explica como utilizar a análise de água para investigar contaminações de origem externa, quais parâmetros indicam cada tipo de problema e como transformar um laudo técnico em evidência para uma ação corretiva ou administrativa.
O que significa uma contaminação de origem externa
Contaminação de origem externa é qualquer alteração na qualidade da água que não tenha como fonte o sistema interno da edificação, como reservatório de água, tubulação, cavalete ou ponto de consumo.
Ela chega de fora: pelo solo, pelo lençol freático, por tubulações que compartilham infraestrutura ou por vazamentos nas proximidades. Na prática, há dois cenários principais:
O primeiro envolve edificações abastecidas por rede pública, onde a contaminação pode entrar pela tubulação de distribuição em caso de rompimento, queda de pressão ou infiltração próxima a redes de esgoto.
O segundo envolve imóveis com poço artesiano ou semi-artesiano, nos quais a qualidade da água subterrânea é diretamente afetada pelo que acontece no solo ao redor.
Os principais agentes e o que cada um indica
A primeira pergunta técnica em uma investigação de contaminação externa é: que tipo de agente está presente na água? A resposta orienta tanto o diagnóstico quanto à responsabilização.
Contaminação microbiológica por coliformes fecais e Escherichia coli
A presença de E. coli na água é o indicador mais direto de contaminação fecal. Quando detectada em um poço ou ponto de consumo sem histórico prévio de não conformidade, a hipótese mais provável é infiltração de esgoto doméstico nas proximidades, seja por fossa séptica mal dimensionada, seja por vazamento em rede coletora do vizinho.
O detalhe que diferencia os coliformes totais de E. coli é decisivo aqui: os coliformes totais podem ter origem ambiental; a E. coli aponta especificamente para fezes humanas ou de animais de sangue quente.
O que vemos na Microambiental: Solicitações de investigação por suspeita de vazamento de esgoto aumentam após períodos de chuva intensa. A explicação é técnica — a elevação do lençol freático facilita o carregamento de contaminantes fecais até poços mais rasos, ampliando o sinal no laudo.
Contaminação química por nitrato e nitrito
Nitrato acima de 10 mg/L (o Valor Máximo Permitido pela Portaria GM/MS 888/2021) em água de poço é um dos indicadores mais consistentes de contaminação por esgoto doméstico ou por fertilizantes nitrogenados.
O nitrogênio proveniente da decomposição de matéria orgânica fecal se converte em nitrito e depois em nitrato ao percolar pelo solo.
Um resultado elevado desse parâmetro, especialmente quando combinado com a detecção de E. coli, aponta forte correlação com uma fonte fecal próxima.
Contaminação por hidrocarbonetos e compostos orgânicos
Quando a suspeita recai sobre atividade industrial ou de posto de combustível nas proximidades, os parâmetros relevantes são outros: benzeno, tolueno, etilbenzeno, xilenos (grupo BTEX) e derivados de petróleo.
Esses compostos são detectados em análises orgânicas específicas e têm VMPs individuais definidos pela Portaria 888. Um único evento de vazamento de tanque subterrâneo pode contaminar o lençol freático por anos.
Turbidez e cor fora do padrão
Turbidez elevada acima de 1 NTU na saída do tratamento, combinada com alteração de cor pode indicar que partículas em suspensão, sedimentos ou matéria orgânica estão chegando à água por uma via não prevista.
Em obras no entorno, a movimentação do solo pode alterar o fluxo do lençol e introduzir argila e sedimentos no poço.
Onde os problemas surgem com mais frequência
A proximidade entre tubulações de água e de esgoto é uma realidade na maioria das infraestruturas urbanas consolidadas.
Quando há diferença de pressão entre as duas redes há uma situação comum em quedas de pressão na rede pública, onde o risco de contaminação cruzada aumenta.
Sinal de alerta: Se a alteração na qualidade da água coincide com o início de uma obra vizinha, com uma queda de pressão relatada pela concessionária ou com um período de chuva acima do normal, esses eventos são dados contextuais relevantes para o laudo. Registre datas e relacione com os resultados analíticos.
Em imóveis com poço artesiano, a vulnerabilidade varia com a profundidade. Poços rasos (até 20 metros) captam o lençol freático superficial, que é o mais exposto a contaminações por fossas, esgotos e produtos químicos do solo.
Poços semi-artesianos (20 a 60 metros) já apresentam melhor proteção natural, mas ainda podem ser afetados por fontes contaminantes com alto volume ou por longos períodos de exposição.
Poços artesianos profundos, que captam diretamente no aquífero, oferecem a maior proteção, mas não são imunes.
O que a legislação prevê e o que o gestor precisa saber
A Portaria GM/MS nº 888/2021 estabelece os parâmetros de potabilidade aplicáveis a todos os sistemas de abastecimento, incluindo soluções alternativas como poços.
Para edificações que utilizam poço como fonte, a norma define a obrigação de análise semestral da água bruta antes do tratamento e da água distribuída internamente.
Esses laudos periódicos cumprem uma função dupla: garantir a conformidade corrente e criar um histórico documentado.
É justamente esse histórico que permite identificar quando uma não conformidade é nova, e portanto possivelmente decorrente de um evento externo ou recorrente, o que aponta para um problema interno.
Erro comum: Muitos gestores só solicitam análise depois de perceber alteração sensorial na água cheiro, cor, gosto. Contaminantes como nitrato, bactérias e compostos orgânicos podem estar presentes em concentrações prejudiciais à saúde sem alterar nenhuma característica visível ou olfativa da água. A análise laboratorial é o único instrumento que identifica esses riscos.
Para os casos em que a suspeita de contaminação por terceiros precisa ser comprovada para fins legais ou administrativos, o laudo emitido por laboratório habilitado pela ANVISA e acreditado conforme NBR ISO/IEC 17025 tem rastreabilidade técnica e é aceito por órgãos reguladores como evidência formal.
Como conduzir a investigação na prática
Uma investigação de contaminação externa segue uma lógica de exclusão e correlação. O objetivo é descartar causas internas, identificar os parâmetros alterados e relacionar os resultados com a fonte suspeita.
Primeiro passo: análise de referência
Antes de qualquer conclusão, é necessário ter um resultado atual da água no ponto de consumo. Esse é o ponto de partida. Se há laudos anteriores sem não conformidade, eles servem como base comparativa.
Segundo passo: escolha dos parâmetros corretos
A investigação não se faz com um escopo genérico. O conjunto de análises precisa ser direcionado para a hipótese em investigação:
- Suspeita de esgoto doméstico ou fossa: coliformes totais, E. coli, nitrato, nitrito e nitrogênio amoniacal
- Suspeita de produto químico industrial ou combustível: compostos orgânicos do grupo BTEX, hidrocarbonetos totais de petróleo (HTP), parâmetros inorgânicos como cromo e chumbo
- Suspeita de obra no entorno ou alteração do solo: turbidez, cor aparente, sólidos em suspensão
Terceiro passo: estratégia de coleta
A coleta em pontos diferentes da mesma edificação pode indicar onde a contaminação entra no sistema.
Analisar a água na entrada do cavalete e nos pontos de consumo permite comparar se o problema existe na entrada, a origem é externa, se aparece apenas nos pontos internos, a causa está no próprio sistema.
Em poços, a coleta deve ser feita diretamente na saída do poço, antes de qualquer reservatório ou tratamento, para que o resultado reflita a qualidade da água subterrânea sem interferência do sistema interno.
O que vemos na Microambiental: Em investigações de suspeita de vazamento de esgoto, a coleta simultânea em dois pontos, na entrada do cavalete e no ponto de consumo mais próximo do poço, é uma das estratégias que mais ajuda a identificar se o problema está no lençol ou se foi introduzido internamente.
Quarto passo: interpretação dos resultados
O laudo precisa ser lido em contexto. Um resultado de nitrato em 8 mg/L, abaixo do VMP de 10 mg/L, pode ser irrelevante isoladamente, ou pode ser significativo se os laudos anteriores indicavam valores próximos de zero. A variação histórica diz tanto quanto o valor absoluto.

O que muda quando a investigação está documentada
Ter um laudo técnico que aponta a origem externa de uma contaminação muda o posicionamento do responsável pela edificação em três dimensões.
Na dimensão da saúde, permite adotar medidas imediatas e cirúrgicas, como a instalação de tratamento específico para o contaminante identificado enquanto a causa raiz é resolvida.
Na dimensão legal, o laudo é o documento que sustenta uma notificação à Vigilância Sanitária.
Na dimensão preventiva, cria o registro que transforma uma ocorrência isolada em dado de monitoramento contínuo.
Os laudos emitidos pela Microambiental ficam armazenados em nuvem e acessíveis via portal do cliente, o que facilita o resgate histórico em situações de auditoria ou disputa administrativa, sem depender de arquivos físicos ou e-mails antigos.
Como a Microambiental apoia a investigação de contaminações externas
Investigações desse tipo exigem metodologia. Isso começa na definição do escopo correto para a hipótese em investigação, passa por uma coleta especializada em campo com equipe própria que garante a integridade das amostras, e termina na interpretação técnica dos resultados com suporte para as ações seguintes.
A Microambiental é integrante da REBLAS (Rede Brasileira de Laboratórios Analíticos em Saúde) e habilitada pelo INMETRO para análises de água potável, com resultados rastreáveis e aceitos por órgãos reguladores.
Para casos que exigem documentação formal, seja para a Vigilância Sanitária, seja para uso jurídico, esse é o ponto de partida correto.
FAQ
Como saber se o vizinho está contaminando minha água de poço?
Uma das soluções mais eficientes de confirmar é por análise laboratorial com escopo direcionado para a hipótese investigada. Se a suspeita é esgoto doméstico, os parâmetros prioritários são E. coli, coliformes totais, nitrato e nitrito. Se a suspeita é produto químico, são necessárias análises orgânicas e inorgânicas específicas. A coleta deve ser feita diretamente na saída do poço, antes de qualquer tratamento interno.
Qual análise identifica contaminação por esgoto na água?
A detecção de Escherichia coli é o indicador mais específico de contaminação fecal. Combinada com nitrato elevado e nitrogênio amoniacal, forma um conjunto analítico consistente para identificar influência de esgoto doméstico ou fossa. Coliformes totais isolados não confirmam origem fecal, a distinção entre coliformes totais e E. coli é tecnicamente relevante nesse contexto.
Com que frequência devo analisar a água de poço artesiano para detectar contaminações externas?
A Portaria GM/MS 888/2021 define a análise semestral da água bruta de poços utilizados como solução alternativa coletiva. Para edificações em áreas com maior risco de interferência externa, proximidade de fossas, obras ou atividades industriais, a frequência pode variar de mensal a trimestral para criar um histórico mais sensível a variações.